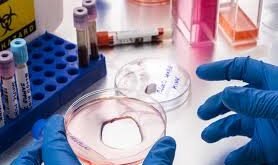

منبر العراق الحر :أفادت الدكتورة ناتاليا ميخائيلفا، أخصائية الأمراض الجلدية والتناسلية أن التعرض المطول للضوء الأزرق المنبعث من شاشات الهواتف الذكية وأجهزة الكمبيوتر والتلفزيون قد يسرع شيخوخة الجلد. وتشير الطبيبة إلى أن التعرض المطول للضوء الأزرق المنبعث من شاشات الهواتف الذكية وأجهزة الكمبيوتر والتلفزيون يسرّع شيخوخة الجلد عن طريق التسبب …
أقرأ المزيدWSJ: إدمان استخدام برامج الدردشة بالذكاء الاصطناعي يرسخ مرض الذُّهان لدى المستخدمين
منبر العراق الحر : نقلت صحيفة وول ستريت جورنال، عن أطباء مختصين، أن تطور الذهان والأوهام لدى المرضى النفسيين قد يكون مرتبطا بالاستخدام طويل الأمد لبرامج الدردشة الآلية التي تعمل بالذكاء الاصطناعي. ونقلت الصحيفة عن الطبيب النفسي كيث ساكاتا من جامعة كاليفورنيا، الذي يعالج مرضى مصابين بالذهان يعتقد أن سبب …
أقرأ المزيدالسيروتونين يفاقم أعراض انفصام الشخصية ويعيق التعافي!.. والعلماء يجدون الدليل
منبر العراق الحر :أثبت الباحثون أن زيادة مستويات السيروتونين في اللُّحاء الجبهي ترتبط بأشد مظاهر انفصام الشخصية، وهو اضطراب عقلي يصيب شخصا واحدا من كل 100 شخص حول العالم. وتعد أكثر الأعراض السلبية المسببة للإعاقة هي العزلة الاجتماعية، انخفاض الدوافع للعمل والراحة، وفقدان القدرة على الاستمتاع بالحياة، ما يعيق التعافي والعودة …
أقرأ المزيدمتى تصبح الشامة مقلقة؟.. علامات تستدعي الفحص الطبي فورا
منبر العراق الحر : ووفقا للدكتورة، معظم الشامات غير ضارة، إلا أن بعض التغيرات قد تشكل خطرا على الصحة، لذلك فإن أي تغير مفاجئ في مظهر الشامة أو الإحساس بها يتطلب استشارة الطبيب فورا. وتوضح:“تشمل علامات تحول الشامة إلى ورم خبيث تفاوت اللون وظهور بقع لونية مختلفة، من البني والأزرق إلى الفاتح، …
أقرأ المزيدانخفاض حرارة الجسم.. تهديد للقلب والصحة العامة في الطقس البارد
منبر العراق الحر :أفادت الدكتورة إلفيرا خاتشيروفا، الأستاذة بجامعة بيروغوف الطبية، أن انخفاض درجة حرارة الجسم بشكل حاد إلى أقل من 35 درجة مئوية قد يؤدي إلى مضاعفات صحية خطيرة، وقد يصل إلى حد الوفاة. وأوضحت أن انخفاض حرارة الجسم يشكل خطرا خاصا على القلب والأوعية الدموية، حيث يزيد من …
أقرأ المزيدتكنولوجيا تساعد الروبوتات على قراءة نوايا البشر
منبر العراق الحر : أصبحت الروبوتات جزءاً متزايداً في حياتنا اليومية، من مجالات الرعاية الصحية إلى المساعدة المنزلية. لكن بناء ثقة حقيقية بين الإنسان والروبوت لا يعتمد فقط على الكفاءة التقنية، بل يتطلب قدرة الآلة على فهم البشر ونواياهم. هذا هو جوهر بحث علمي جديد تجريه جامعة مانشستر ضمن مشروع يُعرف باسم …
أقرأ المزيددور وقائي للبكتيريا المعوية ضد مرض السكري
منبر العراق الحر : كشف باحثون من إمبريال كوليدج لندن (ICL) عن مركب تنتجه بكتيريا الأمعاء يمكن أن يحمي الجسم من مرض السكري من النوع الثاني. وأظهرت الدراسة أن ثلاثي ميثيل أمين (TMA)، وهو جزيء صغير تنتجه ميكروبات الأمعاء أثناء تحليلها للكولين الموجود في البيض واللحوم، قد يلعب دورا حيويا …
أقرأ المزيدتجربة جديدة: الأسفلت المدعوم بالطحالب يقاوم الحفر ويقلل الانبعاثات الكربونية
منبر العراق الحر : أظهرت دراسة حديثة أن استخدام الطحالب الدقيقة في تصنيع الأسفلت يحسن مقاومته للضغط والرطوبة، ويقلل التشوهات، مقارنة بالأسفلت التقليدي المعتمد على البيتومين. وأكدت التجارب المختبرية أن الأسفلت المدعوم بزيت الطحالب يستعيد شكله بشكل أفضل، مما يزيد متانة الطبقات الإسفلتية ويطيل عمر الطرق. يُذكر أن البيتومين، وهو …
أقرأ المزيدابتكار محفز محلي الصنع يُحدث ثورة في محطات التزود بالهيدروجين
منبر العراق الحر :طور علماء من معهد “يوفيه” الفيزيائي التقني وجامعة بطرسبورغ الحكومية الكهروتقنية “ليتي” محفزا مبتكرا لمحطات التزود بالهيدروجين، يتيح إنتاج الهيدروجين مباشرة في موقع الاستخدام. ويسمح هذا النهج بالتخلي عن الإمدادات المركزية للهيدروجين وجعل محطات التزود بالهيدروجين مصادر وقود مستقلة، أفاد بذلك المكتب الصحفي لجامعة “يوفيه” في بطرسبورغ، …
أقرأ المزيداكتشاف عوازل حرارية طبيعية في باطن الأرض
منبر العراق الحر : اكتشف علماء صينيون مناطق غامضة في باطن الأرض على عمق نحو 2900 كيلومتر، بالقرب من حدود اللب والوشاح، تعمل كعازل حراري طبيعي هائل. وتعرف هذه المناطق باسم مناطق السرعة المنخفضة جدا (ULVZs)، وهي صغيرة نسبيا لا يتجاوز قطرها مئات الكيلومترات، وتثير اهتمام علماء الجيوفيزياء بسبب سرعتها …
أقرأ المزيد منبر العراق الحر منبر العراق الحر
منبر العراق الحر منبر العراق الحر